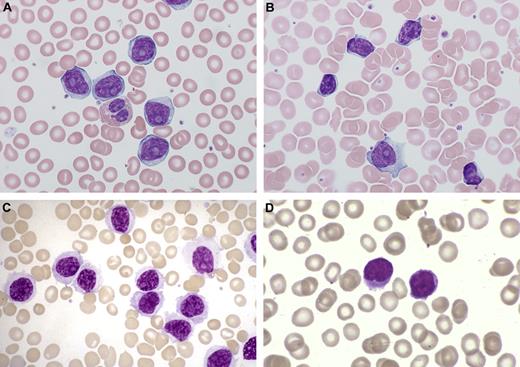
Figure 7. PB morphology of 4 different B-cell leukemias. (A) B-PLL, showing monomorphic prolymphocytes (PL) with condensed chromatin, prominent nucleolus, and scanty basophilic cytoplasm. (B) CLL/PL showing a single prolymphocyte (PL), and several typical CLL cells, which are half the size of the PL, have less cytoplasm and no nucleolus. (C) HCL-V showing cells with condensed chromatin and a conspicuous single nucleolus, but with more abundant pale cytoplasm with cytoplasmic projections. (D) SMZL showing lymphocytes with short polar villi and basophilic cytoplasm.

Abstract
T- and B-cell subtypes of prolymphocytic leukemia (PLL) are rare, aggressive lymphoid malignancies with characteristic morphologic, immunophenotypic, cytogenetic, and molecular features. Recent studies have highlighted the role of specific oncogenes, such as TCL-1, MTCP-1, and ATM in the case of T-cell and TP53 mutations in the case of B-cell prolymphocytic leukemia. Despite the advances in the understanding of the biology of these conditions, the prognosis for these patients remains poor with short survival and no curative therapy. The advent of monoclonal antibodies has improved treatment options. Currently, the best treatment for T-PLL is intravenous alemtuzumab, which has resulted in very high response rates of more than 90% when given as first-line treatment and a significant improvement in survival. Consolidation of remissions with autologous or allogeneic stem cell transplantation further prolongs survival, and the latter may offer potential cure. In B-PLL, rituximab-based combination chemo-immunotherapy is effective in fitter patients. TP53 abnormalities are common and, as for chronic lymphocytic leukemia, these patients should be managed using an alemtuzumab-based therapy. The role of allogeneic transplant with nonmyeloablative conditioning needs to be explored further in both T- and B-cell PLL to broaden the patient eligibility for what may be a curative treatment.
Introduction
Prolymphocytic leukemias (PLLs), first described in the 1970s, are rare mature lymphoid disorders of B- and T-cell subtypes with distinct features and an aggressive clinical course.1-3 Relevant oncogenes, such as T-cell leukemia-1 gene (TCL-1) and ataxia telangiectasia-mutated gene (ATM) in the case of T-PLL, and TP53 in B-PLL have been identified and shown to play a role in the pathogenesis of these disorders. Despite advances in understanding of the biology and pathogenesis, the prognosis for this group remains poor with early relapse and short overall survival (OS). The use of the monoclonal anti-CD52 antibody, alemtuzumab, has improved the outcome and survival in T-PLL, allowing for high-dose therapy options aimed at eradicating the disease. In B-PLL, the approach to treatment is similar to that used in chronic lymphocytic leukemia (CLL). Because of the distinct pathologic features and different therapeutic strategies for B- and T-cell PLL, I discuss them separately.
T-PLL
T-PLL is a rare mature postthymic T-cell neoplasm. In our experience, it accounts for up to one-third of mature T-cell malignancies with a leukemic presentation, but these account for only a very small percentage of all lymphoid malignancies. Clinicians will often only see a case of T-PLL once every 5 to 10 years, which makes recognition of the disorder difficult. The necessary starting point, therefore, before addressing the question of treatment, is to discuss the clinical presentation, the importance of selecting the appropriate diagnostic tests, and the interpretation of test results to arrive at a correct diagnosis. This is essential because the treatment approach is tailored to T-PLL very specifically and would not be that adopted for other T-cell malignancies. Patients are sometimes incorrectly diagnosed and have poor outcomes as a result.
Recognizing the clinical features
T-PLL typically follows an aggressive clinical course from presentation (Table 1). A minority of patients (∼ 15%) may be asymptomatic at diagnosis, and this “indolent” phase can persist for a variable length of time, which may extend to several years.4 However, progression is inevitable and may be very rapid when it occurs. This is a disease of older adults (median age, 61 years) and occurs more frequently in males (male/female = 2:1). Splenomegaly is the commonest finding on examination, occurring in approximately two-thirds of patients. Almost half have hepatomegaly and/or lymphadenopathy, although these are rarely bulky.5,6 Skin manifestations are not uncommon (∼ 20% of patients) and include skin nodules (Figure 1A), maculopapular rash, or, more rarely, erythroderma. Peripheral edema, particularly periorbital and/or conjunctival (Figure 1B), occurs relatively frequently and seems to be particularly characteristic of T-PLL. Other features, which may be seen at presentation or during evolution, include pleuroperitoneal effusions and CNS involvement. There is usually a marked PB lymphocytosis, often in excess of 100 × 109/L with greater than 90% of the circulating cells being prolymphocytes. Anemia and thrombocytopenia are seen in half the cases. Lactate dehydrogenase levels are usually elevated, but hypercalcemia, common in HTLV-I related adult T-cell/leukemia lymphoma (ATLL), is not a feature of T-PLL. Serology and/or DNA analysis for HTLV I and II are consistently negative, and these retroviruses are not implicated in the pathogenesis of the disease.7
Clinical features of T-PLL. (A) Nodular skin infiltration. (B) Periorbital and conjunctival edema.
Clinical features of T-PLL. (A) Nodular skin infiltration. (B) Periorbital and conjunctival edema.
Rarely, the diagnosis of T-PLL is made in a patient with a preceding history of an inherited genetic disorder, and I have seen patients with prior ataxia telangiectasia and Nijmegen breakage syndrome. There are no other familial or geographic predisposing features.
Making an accurate diagnosis
Confirmation of the diagnosis requires a systematic approach and careful integration of the results of morphology with specialized diagnostic tests, including immunophenotyping and cytogenetics.
Morphology.
Examination of the PB film is a key diagnostic test and will often provide the first clue to the diagnosis.8 Prolymphocytes are medium-sized cells with a high nuclear-cytoplasmic ratio (Figure 2). In 50% of the cases, the cells have a round to oval nucleus; whereas in the remainder, the nuclei are irregular, often with convolutions, although less pronounced, than those seen in Sézary or ATLL cells. In typical T-prolymphocytes, the nuclei have a single prominent nucleolus and intensely basophilic agranular cytoplasm with cytoplasmic protrusions. Two variants, small cell and cerebriform, are seen in approximately 20% of cases. Both these variants have immunophenotypic, cytogenetic, and clinical features, which are similar to typical T-PLL.
PB morphology from a typical case of T-PLL showing medium-sized lymphoid cells with a regular nuclear outline, single nucleolus, and intense basophilic cytoplasm. An occasional cell shows a cytoplasmic protrusion.
PB morphology from a typical case of T-PLL showing medium-sized lymphoid cells with a regular nuclear outline, single nucleolus, and intense basophilic cytoplasm. An occasional cell shows a cytoplasmic protrusion.
Morphology of other tissues (eg, BM and lymph nodes) is less informative and may not clearly discriminate between this and other peripheral T-cell malignancies. These tests are therefore not essential to establish a diagnosis. Infiltration of the marrow with prolymphocytes is with a mixed pattern (diffuse and interstitial), and reticulin fibrosis is almost always present. Spleen histology shows expansion of both the red and white pulp with atrophy of the follicular centers. Infiltration of the lymph nodes is diffuse; and in some cases, there is paracortical expansion. The skin histology is very characteristic with dermal infiltration, preferentially around the appendages and sparing the epidermis.
Immunophenotyping.
Immunophenotyping by flow cytometry demonstrates the postthymic T-cell nature (TdT−, CD1a−, CD5+, CD2+, CD7+) of the prolymphocytes. In our Royal Marsden Hospital series of more than 150 cases, the most common phenotype is CD4+/CD8− (60% of cases), but coexpression of CD4/CD8 is seen in 25% (Figure 3) of cases and a minority express CD8 alone.5,6 More than two-thirds of cases express CD3 and TCR-β in the cell membrane, whereas the remainder are negative with either one or both markers.5 In the third of cases lacking surface expression of CD3 and TCR-β, these T cell–specific molecules are consistently expressed in the cytoplasm and the TCR-β and/or γ chain genes are rearranged in all cases.9 T-prolymphocytes express CD7 with strong intensity in contrast to other mature T-cell leukemias, where this marker is often weakly positive or negative (Table 2). CD52 is expressed at high density, explaining to some degree the in vivo sensitivity to the anti-CD52 monoclonal antibody alemtuzumab.10 Cell surface antigens linked to T-cell activation, such as CD25, CD38, and class II HLA-DR, may be variably expressed, but markers identifying cytotoxic T cells, such as TIA-1, are negative, even in cases with a CD8+ phenotype11
Flow cytometry in T-PLL showing negative membrane expression of CD3, strong expression of CD7 and CD5, and coexpression of CD4 and CD8. Courtesy of Ricardo Morilla (Royal Marsden Hospital).
Flow cytometry in T-PLL showing negative membrane expression of CD3, strong expression of CD7 and CD5, and coexpression of CD4 and CD8. Courtesy of Ricardo Morilla (Royal Marsden Hospital).
Genetics.
Recurrent chromosomal abnormalities involving chromosome 14 are present in almost 75% of T-PLL cases, with inversion 14 being the commonest (Figure 4A).12 Tandem translocations between the 2 chromosomes 14, t(14;14), are also present in some cases. Both rearrangements result in activation and expression of the proto-oncogene TCL-1 (Figure 4B).13 It is also possible to test for TCL-1 protein expression using a flow cytometry technique, which confirms positivity in the majority of T-PLL cases. However, assessment of TCL-1 is not routinely available, and lack of this test result should not affect the ability to accurately make a diagnosis or influence the choice of treatment. Another common translocation, t(X;14) (q28;q11), seen in 20% of patients, involves rearrangement of the TCR α locus with the MTCP1 gene (belonging to the TCL-1 gene family; Figure 4B).14 Trisomy 8 or iso8q is seen in up to two-thirds of cases (Figure 4A).15 The C-MYC localized at 8q24 is not rearranged in these cases, but the encoded protein may be overexpressed. Although 11q23 abnormalities are rarely detected on cytogenetics, molecular analysis frequently detects abnormalities of the ATM gene. There are several other recurrent regions of chromosomal abnormalities: loss at 22q, 13q, 6q, 9p, 12p, and 17p and gains at 22q and 6p.16,17
Genetics in T-PLL. (A) Complex karyotype from a case of T-PLL showing the characteristic abnormalities of inversion 14 and trisomy 8 [gain of whole chromosome rather than i(8q)]. The karyotype is 47,XX, +8, del12(p13.1p13.3), inv(14) (q11q32). (B) The deregulation of the oncogenes TCL-1 (chromosome 14) and MTCP-1(X chromosome) through translocations involving the TCR alpha locus on chromosome 14. Courtesy of John Swansbury (Royal Marsden Hospital).
Genetics in T-PLL. (A) Complex karyotype from a case of T-PLL showing the characteristic abnormalities of inversion 14 and trisomy 8 [gain of whole chromosome rather than i(8q)]. The karyotype is 47,XX, +8, del12(p13.1p13.3), inv(14) (q11q32). (B) The deregulation of the oncogenes TCL-1 (chromosome 14) and MTCP-1(X chromosome) through translocations involving the TCR alpha locus on chromosome 14. Courtesy of John Swansbury (Royal Marsden Hospital).
The combination of such distinctive clinical, morphologic, immunophenotypic, and cytogenetic features usually means that the diagnosis, once entertained, is very straightforward. Other than CD52 and TCL-1 expression, none of these laboratory characteristics appears to correlate with outcome.
Differential diagnosis
T-PLL can readily be distinguished from its B-cell counterpart by immunologic markers. Furthermore, skin infiltration and lymphadenopathy are unusual in B-PLL, although they are present in a substantial proportion of T-PLL patients. To discriminate between T-PLL and other T-cell malignancies, including T-cell large granular lymphocytic leukemia, ATLL, Sézary syndrome (SS), and peripheral T-cell lymphoma (PTCL), it is crucial to integrate all the clinical and laboratory information (PB morphology, histology, immunologic and genetic markers; Table 2). Reliance on only 1 or 2 parameters may lead to an incorrect diagnosis. For example, a 73-year-old man was referred to me with a diagnosis of refractory PTCL-unspecified. He had initially presented with a lymphocytosis detected on a routine FBC. Mild splenomegaly was detected on CT. Lymphocytes had a CD3+, CD4+, and CD5+ (CD7 not done), CD8− and CD25− phenotype and cytogenetics showed a complex karyotype with inversion 14. However, the BM trephine biopsy was reported as PTCL-unspecified. He was treated with cyclophosphamide, doxorubicin, vincristine, and prednisolone (CHOP) on which he progressed. After referral, we confirmed a diagnosis of T-PLL; he was treated with alemtuzumab and remains in complete remission (CR) 27 months later. The mistake here was to rely on BM histology rather than a careful examination of the PB morphology and a failure to integrate the results from all the other investigations.
Of note, the term T-CLL has been used in the past (now recognized as the small cell variant of T-PLL) but is no longer a category recognized in the WHO classification and should be avoided because it inaccurately suggests that T-PLL is the T-cell equivalent of CLL. The following example illustrates how misleading this can be: a 77-year-old man was first noted to have a mild lymphocytosis when under the urology team for treatment of a benign bladder tumor. The film was reported as “probable CLL,” but no further tests were done. At his postoperative follow-up, the lymphocyte count was noted to have risen, immunophenotyping was undertaken, reported as “T-CLL,” and 6-month follow-up was recommended. Within a month, he presented with an acute-onset of third, fourth, and sixth cranial nerve palsies. He was referred to neurology where he underwent several investigations, including lumbar puncture (but without immunophenotyping) and brain MRI, which were inconclusive. He was treated with steroids for assumed vasculitis without symptomatic improvement. No connection was made between his hematologic and neurologic conditions. His white blood cells (WBCs) had also increased significantly, and he was referred for an urgent second opinion when we were able to make a diagnosis of T-PLL with CNS involvement. MRI showed clear evidence of meningeal enhancement, and lumbar puncture contained T-lymphocytes with the same aberrant phenotype as those in the PB. He commenced treatment with intravenous alemtuzumab and intrathecal therapy (methotrexate, cytarabine, and hydrocortisone ×6), achieving CR with complete resolution of his neurologic impairment. He remains well and in remission 6 years later. We have had patients referred with a diagnosis of acute lymphoblastic leukemia because of the aggressive presentation, very high WBC, and an immunophenotype negative for membrane CD3 and with dual positivity for CD4 and CD8. I have also seen a patient presenting with skin involvement and lymphocytosis in whom a diagnosis of T-PLL had been made, which on careful review was revised to that of SS. Histology of the skin biopsy was particularly helpful in this case.
What I tell patients about prognosis
There is little information regarding prognostic factors in T-PLL. In our dataset, biologic parameters, such as immunophenoype, cytogenetics, and moleclular genetics, do not influence survival or response to therapy. The most important predictor of outcome is response to alemtuzumab therapy. In this regard, patients with extramedullary disease (eg, liver, CNS, pleuroperitoneal effusions) have lower response rate to alemtuzumab. In our series of 86 patients treated with alemtuzumab, nonresponders had a median survival of only 4 months. In the only other large series reported from The MD Anderson Cancer Center, 5-year survival from diagnosis was 21% and poorer outcome was associated with high WBC, short lymphocyte doubling time, older age, and high expression of TCL-1 protein measured by flow cytometry and immunohistochemistry.18 Patients will often be aware from their reading of the literature that this is an aggressive leukemia with poor OS. However, this information is largely based on retrospective data, and the outlook has improved with the introduction of newer treatment approaches. Even in some of my older patients (older than 80 years), survival has exceeded 5 years after single-agent alemtuzumab; and in some younger patients who have undergone HSCT, remissions have exceeded 10 years. In the future, there is some hope that survival will improve further with the availability of additional effective therapies.
How I treat T-PLL
How I manage “indolent” T-PLL
In those patients presenting with an asymptomatic lymphocytosis that is relatively stable or only slowly progressive, I am happy to monitor until evidence of disease progression. However, the progression may occur rapidly, and I therefore monitor these patients more closely than I would a patient with stage A CLL. This will often allow time to identify a suitable donor if allogeneic transplant is planned so that there will be no delays once treatment with alemtuzumab is initiated. The duration of an indolent phase is variable, but it is unusual for it to persist for more than 1 to 2 years.
How I treat patients requiring first therapy
More typically, patients with T-PLL present with an aggressive clinical picture, and the disease is usually resistant to conventional chemotherapy and can be rapidly fatal. Currently, the best treatment is alemtuzumab followed by consolidation with a stem cell transplant where possible. This approach has led to an extension of the median survival from 7 months in our historic series of more than 70 patients treated with conventional chemotherapy to more than 4 years for those patients receiving alemtuzumab followed by HSCT. I follow the algorithm in Figure 5.
Alemtuzumab (Campath-1H) is a humanized IgG1 antibody, which targets the CD52 antigen that is highly expressed on normal and malignant T- and B-lymphocytes and monocytes but not on hemopoietic stem cells.19 The CD52 antigen is expressed at particularly high density on T-PLL cells10 The mechanism of action of alemtuzumab in vivo is not fully elucidated, but in vitro the antibody can induce cell death by antibody-dependent cellular cytotoxicity, complement activation, and possibly also through direct apoptosis. We have previously reported the results of a study using intravenous alemtuzumab at the standard dose of 30 mg 3 times a week until maximal response in 39 previously treated relapsed/refractory patients, which showed 60% CR and 16% partial remission (PR).20,21 Median disease-free interval after therapy was 7 months (range, 4-45 months). Longer follow-up of this series shows a median survival of 2 years for those patients achieving a CR and 9 months for those in PR. We have now treated a total of 86 T-PLL patients with single-agent alemtuzumab (Table 3): 45 previously treated patients and 41 who were therapy-naive. Nine of the patients treated first-line were enrolled on a pilot study to evaluate the subcutaneous route of administration of alemtuzumab.22 Although data from CLL suggest that subcutaneous alemtuzumab has equal efficacy compared with intravenous administration, we found that this was not the case in T-PLL. The pilot study was terminated early because of the dramatic decrease in response rates associated with the change to subcutaneous administration. Intravenous alemtuzumab results in overall response rates (ORR) in excess of 90% with 81% CRs when given to previously untreated patients with T-PLL (Table 3).22 The ORR fell to only 33% when the antibody was administered subcutaneously. It was possible to rescue a proportion of these patients by switching to intravenous administration and/or adding pentostatin, but 2 of 9 patients died on treatment. The probable reason for this poor result is the longer delay in achieving peak antibody levels via the subcutaneous route,23,24 which may be critical in this rapidly progressive leukemia. Alternatively, the poor result may be because subcutaneous administration in a previously untreated patient could be sufficiently immunogenic to induce neutralizing antibodies. This is the only study that has examined the use of subcutaneous alemtuzumab, but the effects were so striking that, on the basis of these results, I always use intravenous administration of alemtuzumab in patients with T-PLL.
Skin disease responds very well to alemtuzumab therapy, and there is also experience of good efficacy of single-agent alemtuzumab in SS. However, for patients with CNS disease, it is necessary to administer CNS-directed therapy, either triple (methotrexate 12.5 mg, cytarabine 50 mg, and hydrocortisone 12.5 mg) intrathecal, or high-dose systemic methotrexate (3 g intravenous) depending on the distribution of disease. We do not use routine CNS prophylaxis.
We have found alemtuzumab to be well tolerated in this patient population with fewer infectious complications than when it is used in the relapsed CLL patient group (∼ 10% in T-PLL vs 40% in CLL in our institution). Careful attention to infection prophylaxis for Pneumocystis jerovicci and herpes viruses together with regular monitoring for CMV reactivation have minimized serious infections. Infusion reactions are common on initiating intravenous therapy but can be readily controlled with the use of premedication and rarely last beyond the first week of treatment. None of our patients has developed tumor lysis.
Thus, alemtuzumab administered intravenously as a single agent will induce remissions in the majority of patients treated first-line, with minimal toxicity. Remarkably, these responses occur regardless of the apparent bulk of the disease at presentation (ie, high WBC, lactate dehydrogenase, and splenomegaly). It is not advisable to use a debulking strategy using steroids or multiagent regimens, such as CHOP, because this is usually ineffective, delays starting more effective antibody therapy, and adds substantially to toxicity.
How I manage slow responders
Treatment failures are in a minority. In those patients where there is a high tumor bulk and the WBC remains elevated 3 weeks or more after initiating treatment, it is reasonable to increase the frequency of alemtuzumab administration to daily (to more quickly saturate the binding sites) and/or to add pentostatin at a dose of 4 mg/m2 once a week for 4 weeks followed by every 2 weeks in responding patients to best response or to a maximum of 12 weeks. Administration of this dose of pentostatin is dependent on adequate renal function. Pentostatin causes more myelosuppresssion than alemtuzumab used alone and is also associated with nausea, which may last up to 72 hours after administration of the dose. The choice of pentostatin is based on our prior experience with this as a single agent.25 The addition of an alternative purine analog or a novel therapy may provide equivalent or superior disease control, but currently the data on combination regimens are limited. Extramedullary disease, such as serous effusions and liver involvement, more often predict for resistance to alemtuzumab monotherapy, but this can frequently be overcome by the addition of a purine analog, such as pentostatin.
Who should have an HSCT
The main challenge as a clinician treating T-PLL is to deliver long-term disease-free survival. Although some responses with alemtuzumab are very prolonged (> 5 years) longer-term follow-up on patients treated with alemtuzumab in our series suggests that all patients do eventually relapse21 (Figure 6). Experience with both autologous and allogeneic HSCT, although limited, is encouraging.26-32 Single case reports and small series are often misleading because of patient selection bias, and there are only 3 larger reports of hematopoietic stem cell transplantation (HSCT) in the literature. Nevertheless, our experience suggests that consolidation with an HSCT in first or subsequent remission offers potential advantages to patients. We have recently reviewed data on 28 T-PLL patients treated on a common protocol with alemtuzumab followed by either autologous (15) or allogeneic (13) transplantation (Table 4).31 We compared clinical outcomes to 23 retrospectively selected patients who had achieved a CR after alemtuzumab treatment and survived at least 6 months but had not undergone a transplant (non-HSCT group). Apart from age (median 64 years in the non-HSCT group vs 58 years for autograft and 51 years for allograft), the clinical and disease characteristics of the retrospective cohort were the same as those of the patients undergoing HSCT. OS was similar in the autograft and allograft groups at a median of 48 months compared with a median survival for the non-HSCT group of 20 months (Table 4). There was no association between age and survival in either group. We have not seen any failure of engraftment despite the prior use of alemtuzumab, although we usually ensure at least a 3-month period between completing induction treatment and the allo-HSCT. There has been a retrospective review of the European Group for Blood and Marrow Transplantation database with 41 T-PLL patients identified who have undergone an allogeneic HSCT.32 Three-year progression-free survival (PFS) and OS were 19% and 21%, respectively. The 3 year nonrelapse mortality and relapse rate were each 41%, with the majority of relapses occurring in the first year. The main difference between this group of patients and our own allo-HSCT series was the proportion of patients in CR at the time of transplant (11 of 41 for European Group for Blood and Marrow Transplantation series vs 10 of 13 for Royal Marsden Hospital series). In multivariate analysis, factors associated with longer PFS were the use of total body irradiation in the conditioning regimen and a shorter interval between diagnosis and HSCT.
Survival curve for 86 T-PLL patients treated with alemtuzumab. Survivors beyond 72 months are those who received consolidation with a HSCT.
Survival curve for 86 T-PLL patients treated with alemtuzumab. Survivors beyond 72 months are those who received consolidation with a HSCT.
We therefore think that HSCT after alemtuzumab may provide benefit over alemtuzumab alone and is associated with long-term survival (> 5 years) for some patients. The introduction of reduced-intensity conditioning has minimized the transplant-related mortality, and it is hoped that, after longer follow-up, this will translate into improved survival for the allograft group. Of our series of more than 80 patients, almost half of those achieving remission have proceeded to either autologous or allogeneic HSCT (Table 3). One of our patients who only achieved a PR after alemtuzumab received an reduced-intensity conditioning, unrelated donor transplant, and remains in CR more than 10 years later, suggesting that this approach has curative potential. Nevertheless, allografted patients do still have a risk of relapse; and so far, outcome after relapse in our experience has been very poor with no clarity regarding the best relapse treatment or the benefit of DLI. There remains therefore some uncertainty about the optimal strategy for allogeneic HSCT, which would be best addressed by conducting prospective clinical trials that are currently not available. In the absence of such robust data but in the knowledge that allograft may currently provide the only possibility of cure in this disease, I do continue to offer this to all suitable patients in first remission. Allografts, however, are an option only in a proportion (30%-50%) of patients with T-PLL. Autologous HSCT is also a benefit for patients, prolonging remissions with much less treatment-related toxicity than allogeneic HSCT, but not resulting in cure. For those patients who are also ineligible for autologous HSCT, we need to explore other strategies.
Minimal residual disease can be monitored by flow cytometry (aberrant phenotype) or PCR, but as yet there is no evidence that this helps in disease management. All nonallografted patients progress, so the presence of residual disease does not necessarily help to define a higher risk group. Minimal residual disease monitoring has not been explored in the transplant setting but may be more useful here in directing DLI.
Alternative first-line treatments
The rarity of T-PLL has meant that there have been no prospective randomized controlled studies to compare the efficacy of different therapies. Indeed, even nonrandomized studies are mostly retrospective with small patient numbers accrued over prolonged periods of time (Table 5). Entering patients into clinical trials is to be encouraged. However, currently there are no prospective front-line studies open.
Historically, patients were treated with alkylating agents, such as chlorambucil, or combinations, such as CHOP, with only a minority (< 30%) of short-lived responses (3 months) and a dismal median survival of only 7 months.5 This approach should therefore be avoided because of lack of efficacy.
The advent of purine analogs, such as pentostatin, fludarabine, and cladribine (2CDA), improved response rates and in some cases induced a durable remission enabling the patient to undergo a stem cell transplant. In our Royal Marsden Hospital series of 56 predominately relapsed/refractory T-PLL patients treated with pentostatin, the ORR was 45% with 9% achieving CR.25 Median duration of response was only 6 months, but survival was improved for responders compared with historical controls.
The successful use of chemoimmunotherapy in B-cell malignancies prompted similar studies in T-PLL. The German CLL study group have conducted a prospective phase 2 trial in 25 patients with previously treated (9) and treatment-naive (16) T-PLL.33 The sequential therapy composed up to 4 cycles of fludarabine, mitoxantrone, and cyclophosphamide (FMC) given every 4 weeks followed by consolidation with intravenous alemtuzumab 3 times a week in responding patients, one to 3 months after completion of chemotherapy. ORR was 68% after FMC (6CR) and 92% after both therapies. Alemtuzumab consolidation in 21 patients increased the ORR to 95% in these patients (80% of all the trial patients) with a doubling of the CR rate (12 CR). Median OS and PFS were 17 and 12 months, respectively. The MD Anderson Cancer Center has explored the use of alemtuzumab in combination with pentostatin in a range of PTCL, including T-PLL, and found activity (ORR, 69%) similar to that seen with alemtuzumab alone.34 These treatment trials are summarized in Table 5.
However, given the comparable results with single-agent alemtuzumab, I do not think that any of the aforementioned combination strategies offer convincing additional benefit while adding substantially to toxicity. I reserve the addition of a purine analog for those patients failing to respond optimally to antibody treatment alone.
How I treat relapsed refractory T-PLL
Despite the very high RR with alemtuzumab, relapse is inevitable for all but the minority of patients who appear “cured” after allogeneic HSCT. Although improved, median survival remains only 20 months (Figure 6). For those patients who have not previously received alemtuzumab, this is the treatment of choice at relapse and good RRs have been documented in the relapsed/refractory (alemtuzumab-naive) patient group.20,21,35 For those patients who received induction therapy with alemtuzumab, with response duration of at least 6 months, retreatment can be successful in achieving a second, or even third, remission (> 50% of patients will respond a second time), but this is usually of much shorter duration. Occasionally, the T-PLL cells lose expression of the CD52 antigen precluding further use of alemtuzumab.36 I therefore always retest for this at relapse. Maintenance alemtuzumab has not been formally evaluated and is likely to encourage early loss of CD52 expression. For those patients who fail or are unsuitable for alemtuzumab retreatment, I usually use a purine analog-based therapy, but response rates are not high. Nelarabine, with or without fludarabine, is an alternative for which there is some evidence of activity in T-PLL.37 In a phase 1 study in 11 T-PLL patients, ORR was 20% for nelarabine alone, rising to 63% (13% CR) for the combination with fludarabine. If the patient is a suitable candidate for an allogeneic transplant, then it is sometimes possible to induce a remission with an intensive combination regimen and proceed directly to HSCT. With current treatment options, very few patients will have a successful outcome after relapse.
How an understanding of the biology can help in the development of new treatment strategies
Most patients with T-PLL will still die from their disease, and new therapies are badly needed. Knowledge of the disrupted pathways and mechanisms underlying activation and proliferation in T-PLL has raised the possibility of developing a treatment approach that targets these growth and survival signals by the use of small-molecule inhibitors. Potential targets include the following:
ATM.
AKT and TCL-1.
The TCL-1 family oncoproteins augment AKT activation by forming stable complexes at the cell membrane, which allow enhanced signal transduction, cell proliferation, and survival.42 The majority of T-PLL cases have overexpression of TCL-1 and, in a smaller number of cases, of MTCP-1. Potentially, inhibition of AKT prevents its recruitment to the cell membrane and subsequent activation through phosphorylation. This would then have downstream effects on effector functions. Similarly, direct blockade of TCL-1, acting independently or in concert with AKT inhibition, may abrogate the clonal expansion driven by dysregulation of this pathway.
Telomerase.
Extremely short telomeres and high levels of telomerase activity have been reported in T-PLL, and T-PLL cells are sensitive to telomerase inhibition in vitro.43
Other therapeutic targets.
Other intracellular signaling pathways, such as JAK-STAT and IRF, also offer potential targets for inhibition. In addition, there is the possibility of epigenetic modification, with evidence that combinations which include epigenetic drugs can help overcome resistance to alemtuzumab, which has arisen through down-regulation of CD52. The use of high-density genomic mapping and whole-genome sequencing is likely to identify further candidate genes, leading to a better understanding of pathogenesis in T-PLL and a more directed approach to therapy.44-46
How I manage B-PLL
B-PLL is a very rare mature B-cell malignancy with an aggressive clinical course, refractoriness to chemotherapy, and a median survival of 3 years. In the early 1970s, B-PLL was initially described as a variant form of B-cell CLL.47 However, in the WHO classification, it is included as a distinct clinicopathologic entity and defined as a malignancy of prolymphocytes affecting the blood, BM, and spleen.3 B-PLL should be distinguished from “CLL with increased prolymphocytes” (CLL/PL). A small proportion of patients with CLL undergo prolymphocytoid transformation, and PB morphology reveals the presence of a mixture of small mature CLL cells and prolymphocytes in contrast to typical B-PLL where the circulating cells are monomorphic prolymphocytes.
How I recognize the clinical features of B-PLL
This is another leukemia that predominantly affects older people and the median age at presentation of 69 years is close to that of CLL and older than that of T-PLL (Table 1).6 There is only a slight male preponderance, however. Patients often present with advanced disease: B-symptoms, massive splenomegaly, absent or minimal lymphadenopathy, and high WBC count. As in T-PLL, a small proportion of patients have an indolent asymptomatic phase with frank progressive disease within a few months or years. Our experience in 60 cases shows that splenomegaly is the most common feature, but up to one-third of patients have, or develop, small-volume lymphadenopathy.6 However, serous effusions or CNS involvement are rare, and skin involvement, in contrast to T-PLL, is not seen.
How I diagnose B-PLL
True B-PLL is extremely rare, accounting for only approximately 1% of lymphocytic leukemias, and its existence as a separate entity has been debated. The diagnosis is much more challenging than that of the T-cell counterpart because of the considerable overlap with other mature B-cell leukemias and lymphomas, such as mantle cell lymphoma (MCL) or splenic marginal zone lymphoma (SMZL). It is possible that, with the advent of more precise diagnostic tools, it will be possible to attribute cases currently identified as B-PLL to other disease categories.
Morphology.
Careful examination of PB morphology is key to an accurate diagnosis of B-PLL. The prolymphocyte count must be greater than 55% in the PB and usually exceeds 90%. The B-prolymphocyte has a characteristic large size, twice that of a small CLL lymphocyte (Figure 7A). The nuclear chromatin is moderately condensed, there is often a prominent central nucleolus, and the nuclear outline is typically round and more uniform than in CLL or CLL/PLL (Figure 7B). The cytoplasm is more abundant than in CLL, clear, and only weakly basophilic. In contrast to the rarer variant form of hairy cell leukemia (HCL-V; Figure 7C) and the circulating cells in SMZL (Figure 7D), the cytoplasm generally has a smooth outline. BM trephine biopsies are usually required as they provide important diagnostic information. The infiltrate is interstitial and nodular with an intertrabecular distribution. In contrast to CLL, proliferation centers are not seen. Lymph node or spleen histology is rarely necessary to distinguish between B-PLL and CLL but may be helpful if a diagnosis of MCL or other “splenic” lymphomas is considered. In B-PLL, spleen histology shows expanded white pulp nodules and red pulp infiltration with cells of the same morphology as seen in the PB (Figure 8A). The central nucleolus is often very marked in H&E-stained sections (Figure 8B).
PB morphology of 4 different B-cell leukemias. (A) B-PLL, showing monomorphic prolymphocytes (PL) with condensed chromatin, prominent nucleolus, and scanty basophilic cytoplasm. (B) CLL/PL showing a single prolymphocyte (PL), and several typical CLL cells, which are half the size of the PL, have less cytoplasm and no nucleolus. (C) HCL-V showing cells with condensed chromatin and a conspicuous single nucleolus, but with more abundant pale cytoplasm with cytoplasmic projections. (D) SMZL showing lymphocytes with short polar villi and basophilic cytoplasm.
PB morphology of 4 different B-cell leukemias. (A) B-PLL, showing monomorphic prolymphocytes (PL) with condensed chromatin, prominent nucleolus, and scanty basophilic cytoplasm. (B) CLL/PL showing a single prolymphocyte (PL), and several typical CLL cells, which are half the size of the PL, have less cytoplasm and no nucleolus. (C) HCL-V showing cells with condensed chromatin and a conspicuous single nucleolus, but with more abundant pale cytoplasm with cytoplasmic projections. (D) SMZL showing lymphocytes with short polar villi and basophilic cytoplasm.
Histology of the spleen in B-PLL. (A) Low power view (original magnification ×20) showing replacement of the white pulp and infiltration of the red pulp. (B) High power view (original magnification ×100) of the white pulp showing the typical prolymphocyte morphology with abundant cytoplasm, round nuclei, and a central eosinophilic nucleolus. Courtesy of Andrew Wotherspoon (Royal Marsden Hospital)
Histology of the spleen in B-PLL. (A) Low power view (original magnification ×20) showing replacement of the white pulp and infiltration of the red pulp. (B) High power view (original magnification ×100) of the white pulp showing the typical prolymphocyte morphology with abundant cytoplasm, round nuclei, and a central eosinophilic nucleolus. Courtesy of Andrew Wotherspoon (Royal Marsden Hospital)
Immunophenotype.
The presence of a monoclonal B-cell proliferation is confirmed by establishing light chain restriction and the B cells further characterized by use of a panel of immunophenotypic reagents. Importantly, this will rule out the presence of typical CLL (CD5+, CD23+, surface immunoglobulinweak, FMC7−, CD79bweak) or CLL/PLL, which has the same phenotype (Table 6). We use this panel of markers to construct a CLL score.48 Whereas high scores of 4 or 5 are expected in CLL, lower scores of 0 to 1, and rarely 2, are seen in B-PLL. Low scores are also seen in other B-cell leukemias and lymphomas. The cells in B-PLL express various pan B-cell antigens with strong intensity (CD20, CD22, CD24, CD79b, and FMC 7), and surface immunoglobulin (IgM or IgM/IgD) is detected at much higher levels than in CLL. The expression of markers, such as FMC7 and CD11c, suggests that the cells are at a late stage of maturation. Most cases of B-PLL are CD23− and CD5−, although up to 30% may be CD5+ and these cases may be difficult to differentiate from MCL in leukemic phase. In a small number of cases tested, approximately 50% had positive expression of ZAP 70 and CD38, but this did not have a prognostic impact.49
Genetics.
Only a few cytogenetic studies have been reported in B-PLL because of the rarity of the disease and the difficulty of obtaining prolymphocytes in metaphase.50-53 Use of B-cell mitogens might increase the detection rate of cytogenetic changes. Complex karyotypic changes are common. Using interphase FISH, 13q14 deletions, 17p deletions, and monoallelic 11q23 deletions can be identified, but trisomy 12 is rare.51 Other abnormalities described include 6q−, t(6;12), and structural aberrations of 1p and 1q.50 Although t(11;14) has previously been described in B-PLL, it is clear now that these cases represent a leukemic phase of MCL, for which this is the “hallmark” translocation.54 This also highlights the importance of tissue-staining for cyclin D1 and SOX11 in such cases, as PB morphology and immunophenotyping is not always discriminatory. SOX 11 has high sensitivity for MCL, being positive in more than 90% of cases, including those negative for cyclin D1.55 It is negative in most other mature B-cell malignancies tested, but expression can be seen, independent of t(11,14), in up to 50% of cases of HCL and Burkitt lymphoma.56
We have documented mutations of the TP53 gene in more than 50% of the B-PLL cases. This incidence is the highest reported among all the subtypes of B-cell malignancies and is likely to be responsible for the frequent resistance to therapy seen in this disease.57 Approximately half of B-PLL cases have unmutated immunoglobulin heavy chain variable region genes, with usage of V3-23 and V4-34 in one-third of the cases.49 The immunoglobulin heavy chain variable gene usage is different from that of CLL. The majority of TP53 deleted cases are unmutated.
Gene expression profiling demonstrated that B-PLL has a signature quite distinct from that of CLL or CLL/PL.58 Approximately 6000 genes are differentially expressed between CLL and B-PLL, with 75% of these genes showing a greater than 2-fold change in expression. Most overexpressed genes in B-PLL were those involved in cell proliferation/cell cycle, including C-MYC. Chromosomal translocations involving 8q24 [eg, t(8;14)] have been reported in cases of B-PLL, suggesting that C-MYC alterations may be important in the pathogenesis of a subset of these cases.59,60
The above evidence from genetic analysis supports the view that B-PLL is a separate entity, at least in relation to CLL. It is also possible that some of these differences are simply a result of misclassification. As yet, there is insufficient evidence regarding where B-PLL sits in relation to other splenomegalic lymphoproliferative disorders, such as SMZL and HCL-V, in relation to genetic profiling. The cell of origin of these disorders is poorly characterized, and further studies are needed to clarify the relationships between them.
Differential diagnosis
The differential diagnosis of B-PLL is with CLL/PL, leukemic MCL, HCL-V, SMZL, and T-PLL. Immunophenotyping will readily distinguish B-cell from T-cell PLL, even when the clinical presentation and PB morphology are the same. The percentage of PLs, the CLL score, and the presence of proliferation centers in the BM biopsy help to define CLL with an increase in prolymphocytes. True de novo B-PLL does not arise on a background of known CLL. However, there is considerable overlap between the features of B-PLL and several other mature B-cell malignancies with PB involvement, which can make the diagnosis difficult. Integration of the clinical picture with results from morphology, histology, immunophenotype, and genetics, as outlined in the sections above and summarized in Table 6, usually allows separation of these disorders (Figures 7 and 8). The demonstration of t(11;14) and positive expression of cyclin D1 and/or SOX 11 is able to identify cases of MCL with a leukemic presentation. In my experience, the greatest difficulty is with SMZL and HCL-V where the similar clinical presentation (older age, splenomegaly, and lymphocytosis), the overlap in morphologic features (cytoplasmic basophilia, nucleolus in HCL-V, and the loss of the fine “hairy” projections in poorly prepared blood films from HCL-V and SMZL), together with a lack of distinct immunophenotypic or cytogenetic markers, can make precise diagnosis problematic. Spleen histology, when available, can be helpful61 (Figure 8). The presence of B symptoms, very high WBC (> 100 × 109/L), and aggressive clinical course are much more characteristic of B-PLL than of SMZL or HCL-V. The distinction is important therapeutically because many cases of HCL-V and SMZL do not require therapy or may benefit from splenectomy or rituximab monotherapy alone, whereas B-PLL is likely to require a combination chemo-immunotherapy approach.
Prognosis
B-PLL is generally regarded as having a poor prognosis, with historical data suggesting a median OS of approximately 3 years. None of the markers associated with poor prognosis in CLL, other than the presence of TP53 deletions/mutations, appears to influence outcome, although the data are very limited. Furthermore, very little information is available from prospective series in the era of antibody therapy which, as in CLL, may have resulted in significant improvement in survival. The only clear marker of poor outcome remains the presence of TP53 abnormalities, and I would use this, in particular, to influence patient selection for HSCT approaches.
How I treat B-PLL
B-PLL is not only difficult to diagnose but is often difficult to treat. Despite the differences in biology and clinical features, I usually adopt a similar treatment approach as I would to a patient with CLL, after the algorithm in Figure 9. The clinical course is variable and therapy is not indicated in asymptomatic patients.62 However, B-PLL rarely remains indolent for long, in contrast to stage A CLL. Alkylating agents, such as chlorambucil, are of little value in the management of B-PLL. Combination regimens, such as cyclophosphamide, doxorubicin, oncovin, and prednisolone (CHOP), have recorded responses (partial responses and rare CRs) in up to one-third of cases.63 Single-agent purine analogs, such as fludarabine, cladribine, and pentostatin, may achieve responses in 50% of patients, including a minority of CRs, but with few lasting more than 12 months.64,65 There are few data on the use of purine analog combinations in B-PLL.66,67 A phase 2 trial using fludarabine and cyclophosphomide showed an ORR of 50% with a median survival of 32 months.66 There are case reports documenting the successful treatment of B-PLL with the anti-CD20 monoclonal antibody rituximab.68 Combinations of fludarabine or bendamustine with mitoxantrone or epirubicin and rituximab (FMR, FER, and BMR) have also been reported to have activity in B-PLL.69-71 Given the excellent responses seen in CLL and MCL with the combination of fludarabine, cyclophosphomide, and rituximab, my usual approach to fit patients without TP53 abnormalities is to use this regimen as first-line therapy. In my experience, this has induced durable CRs in excess of 5 years. Because bendamustine plus rituximab has been shown to have efficacy in CLL and other B-cell malignancies, this could also be a very suitable therapy and may be associated with less hematologic toxicity.
Alemtuzumab also has potential in B-PLL.72,73 As in CLL, B-PLL patients with TP53 deletions or mutations should be treated with alemtuzumab because this abnormality is associated with primary resistance to purine analog-based therapy. Alemtuzumab is also most active in the blood, BM, and spleen, which are the main sites involved in B-PLL, whereas bulky lymphadenopathy is almost never seen. We have previously reported a CR in a patient with B-PLL after subcutaneous alemtuzumab 3 times a week for 12 weeks.73
Patients presenting with massive splenomegaly and who are not considered fit for systemic treatment or are refractory to chemotherapy may be effectively palliated with splenectomy or splenic irradiation. Not only does splenectomy remove a major proliferative focus and considerable tumor bulk in this disease, but it can also relieve hypersplenism and facilitate further treatment. In frail patients, splenectomy may not be feasible and splenic irradiation may be a suitable alternative.74
Stem cell transplantation should also be considered in younger, fit patients who have responded to their initial therapy, as disease progression is inevitable. Allogeneic HSCT gives patients the possibility of a long-term cure by potentially harnessing a graft-versus-leukemia effect.29,75 However, the morbidity and mortality associated with this procedure are significant, and often it is not a feasible option because of patient age or comorbidities. However, the introduction of nonmyeloablative approaches has widened the eligibility, making this available as a treatment option in a larger cohort of patients.
In conclusion, T-PLL and B-PLL are 2 rare clinically aggressive but distinct disease entities with characteristic morphologic, immunophenotypic, and molecular features.
Therapeutic options for T-PLL have improved with the use of alemtuzumab monoclonal antibody therapy, delivered intravenously, with the majority of patients now achieving durable remissions. However, this treatment is not curative, and remission should be consolidated with stem cell transplant in suitable patients. Rituximab-based chemo-immunotherapy combinations should be considered as first-line therapy for B-PLL with alemtuzumab used for those presenting with abnormalities of TP53. Splenectomy or splenic irradiation may still have a role, especially as palliation. Eligible patients should also be considered for HSCT procedures.
Acknowledgments
The author thanks all her colleagues at the Royal Marsden Hospital and the Institute of Cancer Research, especially Monica Else for data analysis and reviewing the manuscript, Alison and Ricardo Morilla (Figures 3 and 7), John Swansbury (Figure 4A), Andrew Wotherspoon (Figure 8), and Saman Hewamana, Estella Matutes, Mark Ethell, Bronwen Shaw, Mike Potter, and Daniel Catovsky as well as all the collaborators in clinical studies. Most of her gratitude goes to all the patients she has had the privilege to treat, and who, through their willingness to participate in clinical and laboratory research, have given her the opportunity to learn more about these diseases.
Authorship
Contribution: C.D. wrote the manuscript.
Conflict-of-interest disclosure: C.D. has received honoraria from Genzyme, Bayer Schering Pharma, and Roche.
Correspondence: Claire Dearden, Department of Haemato-Oncology, Royal Marsden Hospital, Downs Road, Sutton, Surrey SM2 5PT, United Kingdom; e-mail: claire.dearden@rmh.nhs.uk.



![Figure 4. Genetics in T-PLL. (A) Complex karyotype from a case of T-PLL showing the characteristic abnormalities of inversion 14 and trisomy 8 [gain of whole chromosome rather than i(8q)]. The karyotype is 47,XX, +8, del12(p13.1p13.3), inv(14) (q11q32). (B) The deregulation of the oncogenes TCL-1 (chromosome 14) and MTCP-1(X chromosome) through translocations involving the TCR alpha locus on chromosome 14. Courtesy of John Swansbury (Royal Marsden Hospital).](https://ash.silverchair-cdn.com/ash/content_public/journal/blood/120/3/10.1182_blood-2012-01-380139/4/m_zh89991293820004.jpeg?Expires=1765896660&Signature=txNGBJ8781ijqt4ICTyUvnwwvD0aa4lYtLbIqSpa2mEia1krXzGr2OWzW6bSUOYeP5WFkK~6fYhPBRagRT9rFZUAu-w7qlYaqIowZGwGatjchjORWSYRLA0QWuxPxSD3wUBC-7vXAQZWDQQvpR9ReBIijpf8xCEnclrGXX4MsZsBZv0Dqar2U8kLDfSsMnLSXaiNRZFYFJcG-JVxj~rewtjDe7T9V7Xk~PTRHjb1U-1jUENagkKaoheu-~D98hPAFLDj0YNbB8GLQet~kPyuJUbv9FKAcIJ3E9OO6dr1WFKbX7iL7Xr8NIhoevqErQ7BCog6K~6fR6bB2z20jd67lg__&Key-Pair-Id=APKAIE5G5CRDK6RD3PGA)

![Figure 4. Genetics in T-PLL. (A) Complex karyotype from a case of T-PLL showing the characteristic abnormalities of inversion 14 and trisomy 8 [gain of whole chromosome rather than i(8q)]. The karyotype is 47,XX, +8, del12(p13.1p13.3), inv(14) (q11q32). (B) The deregulation of the oncogenes TCL-1 (chromosome 14) and MTCP-1(X chromosome) through translocations involving the TCR alpha locus on chromosome 14. Courtesy of John Swansbury (Royal Marsden Hospital).](https://ash.silverchair-cdn.com/ash/content_public/journal/blood/120/3/10.1182_blood-2012-01-380139/4/m_zh89991293820004.jpeg?Expires=1766503568&Signature=Nl92OLXSOfatLFMCjxt4oMUJjB9Ly5Z15qFtLCi-QrRCg~3otujB9ZE80IZUGo8aCDFF5IK4gjAz5XP8EbjCro0zo~Q56LjUbUe-vHEj64NDoR-Qzm5D1vcqu3mVnlYTdplocj2pS0tfj841RTM50WOAn1iHrbK7GVtM6sZ4IE-PlrOwrCVSHI1KDkVeKEND8PkmHLyq3x8NAkGtYefttgng2qkHyfdt~79SfyzBb7b7m8RbmyXCagB-HoJ7IUdgH~qvHe7xQeRphQlui315QTPssFmGS9vDpnklX93~091uVlcaXRuSTedPRKIt3kfW~XwCLfb9EhzdNz4Yr1Mjkw__&Key-Pair-Id=APKAIE5G5CRDK6RD3PGA)




